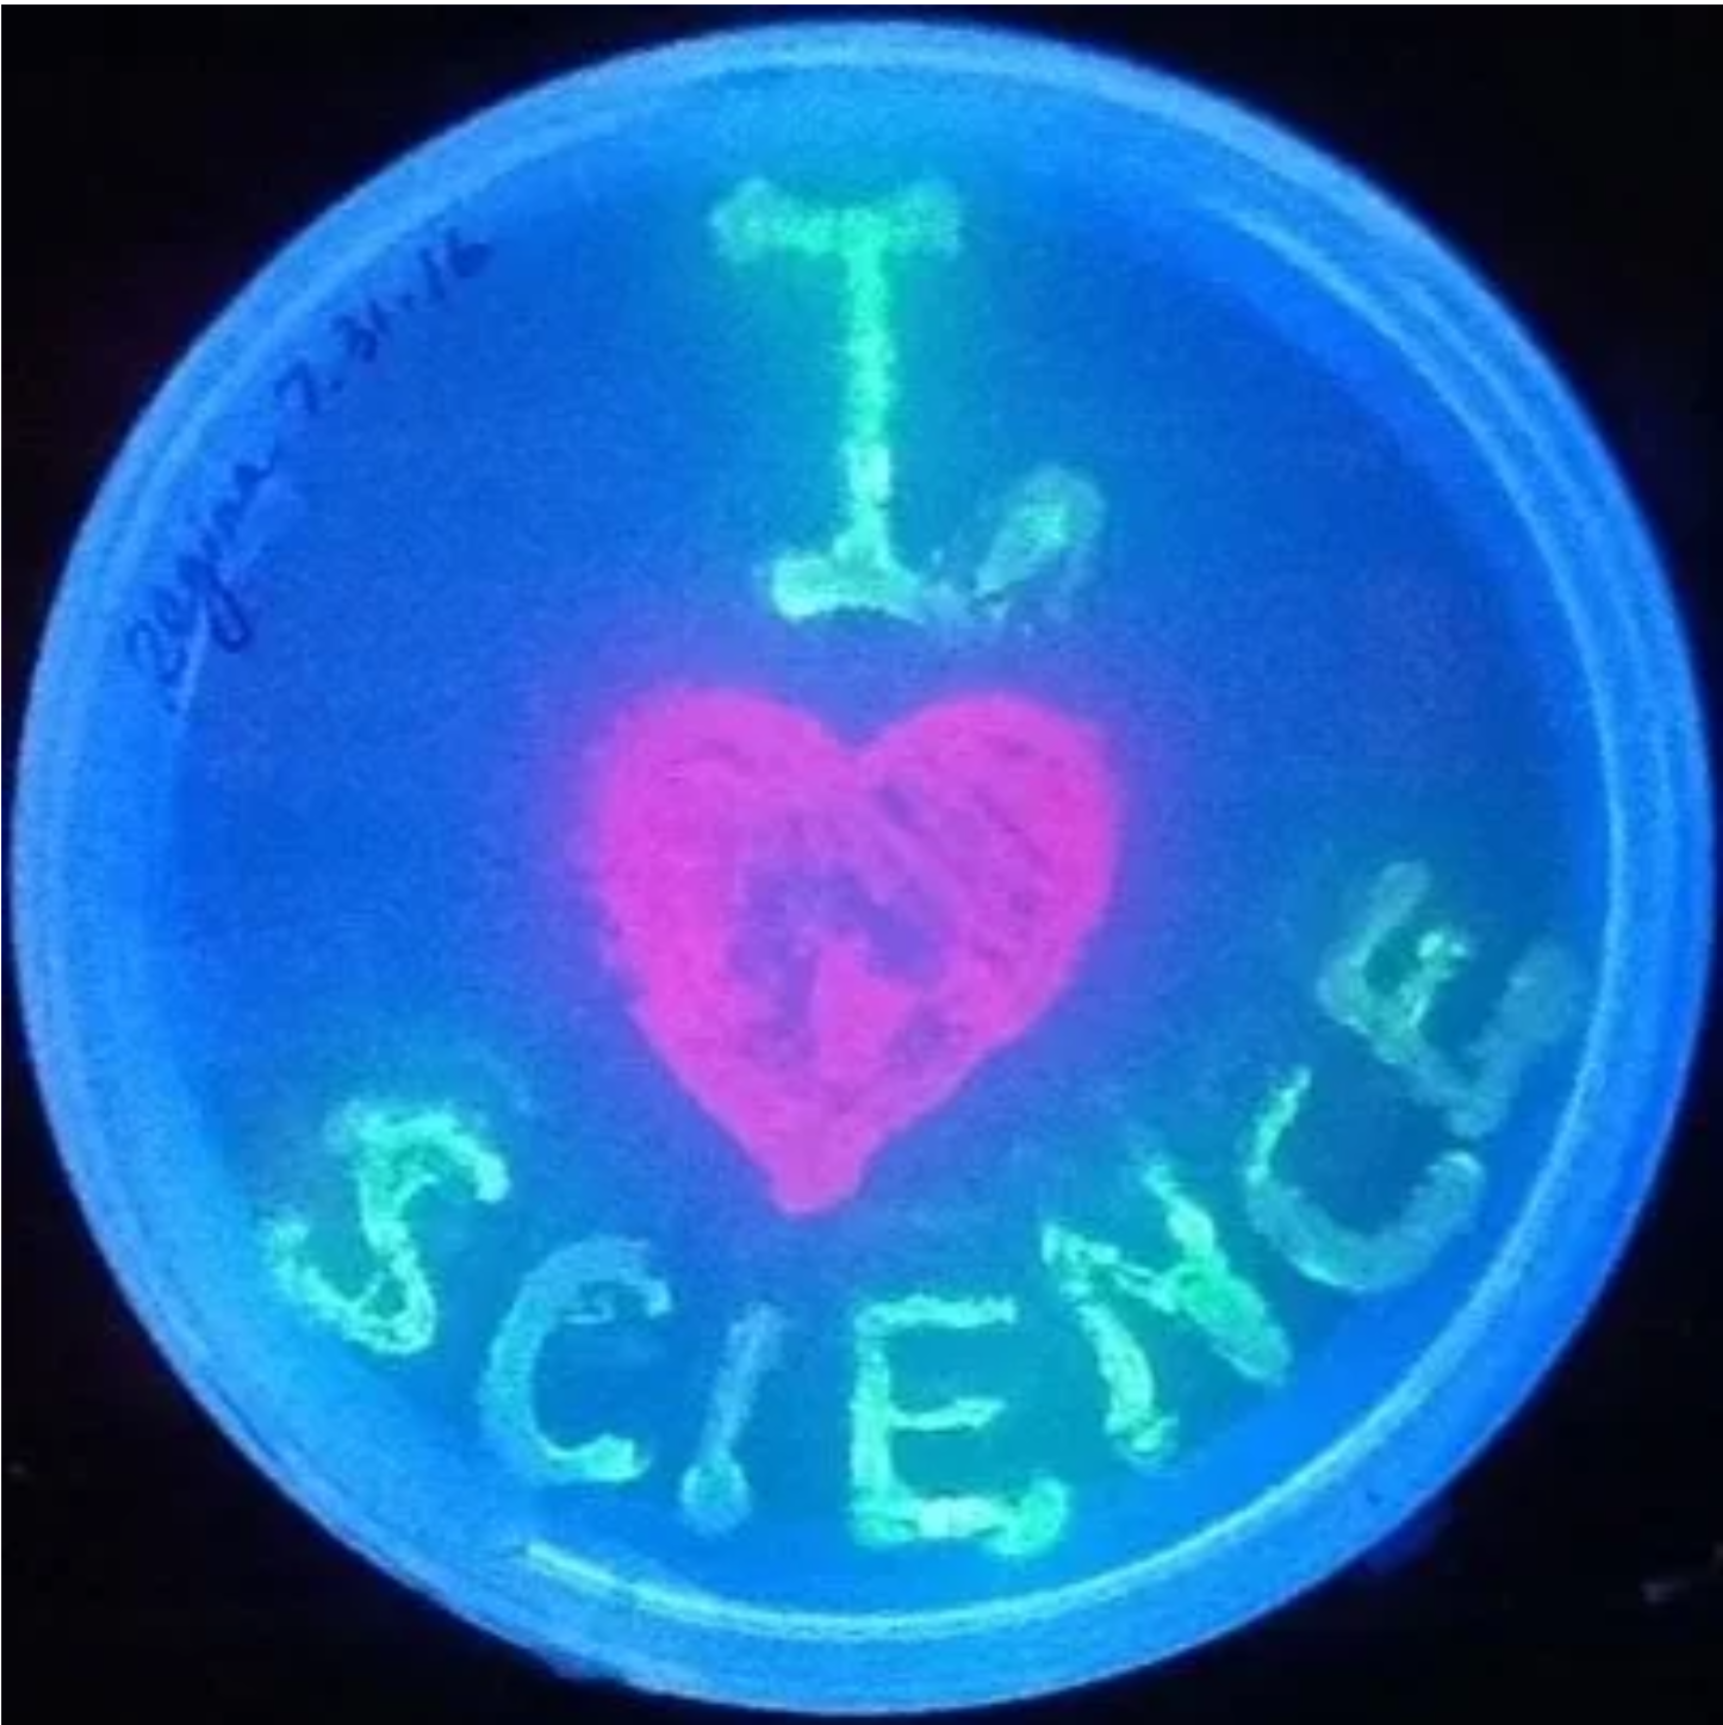
Painting with Bacteria I Love Science .png

About SoundBio Lab
Founded in 2016 by a small collective of DIYBio enthusiasts, SoundBio Lab is a nonprofit community biology makerspace and science education lab in the heart of Seattle’s University District.
Our Vision
A space for anyone to create, dream and explore with science.
Our Mission
SoundBio Lab welcomes everyone to explore and grow their passion for science. We provide space, tools and community to foster original research projects alongside hands-on STEAM education in our biomakerspace and the greater Seattle area.
Who we SERVE
We believe biology isn’t just for professionals in lab coats – it’s for everyone. We support:
Innovators, makers, and entrepreneurs
Teens eager to dive into hands-on activities
College students looking for real-world experience,
Established researchers seeking a new environment
Science-curious community members with no prior biology training.
Our community lab welcomes participants ages 12+ from all backgrounds, while our outreach programming and private events support ages 6 and up.
What we OFFER
Three tiers of membership access to our shared laboratory space for independent and collaborative research
Community projects open to the public
Hands-on courses and workshops that build real-world bench skills for ages 12 through adult
Project-based high school and middle school research experiences at our lab
K-12 outreach programs, bringing hands-on biology to schools, fairs, festivals, and events
Private events for ages 6 through adult, tailored to the age group of the students
Scholarships and fee waivers to expand access to all
Through affordable, hands-on programs, we make bioscience accessible to all ages and backgrounds, sparking curiosity, playfulness, and agency in the sciences.
Our Values
The following values guide the actions and relationships of the SoundBio Lab community, including all volunteers and staff.
Community
We support and are comprised of a diverse and inclusive community. We approach all tasks with a spirit of collaboration and volunteerism, and we recognize the mutual benefit of mentoring and peer-learning.
Integrity
We take our social and ethical responsibilities seriously to ensure the safety of those in and around our lab, be good environmental stewards and work with transparency and honesty.
Equity
We work in opposition to systems of marginalization and oppression that exclude people from STEAM, collaborating with partners to provide equitable access to hands-on science resources and community.
Creativity
We see artistic expression and tinkering as valuable practices that open up creative ways of thinking about and doing science.
Innovation
We practice DIY (Do-It-Yourself) culture! We use the resources at our disposal to push boundaries, make new discoveries, and innovate. Everyone at SoundBio Lab should support a culture of encouragement, growth, and a willingness to learn from failure.